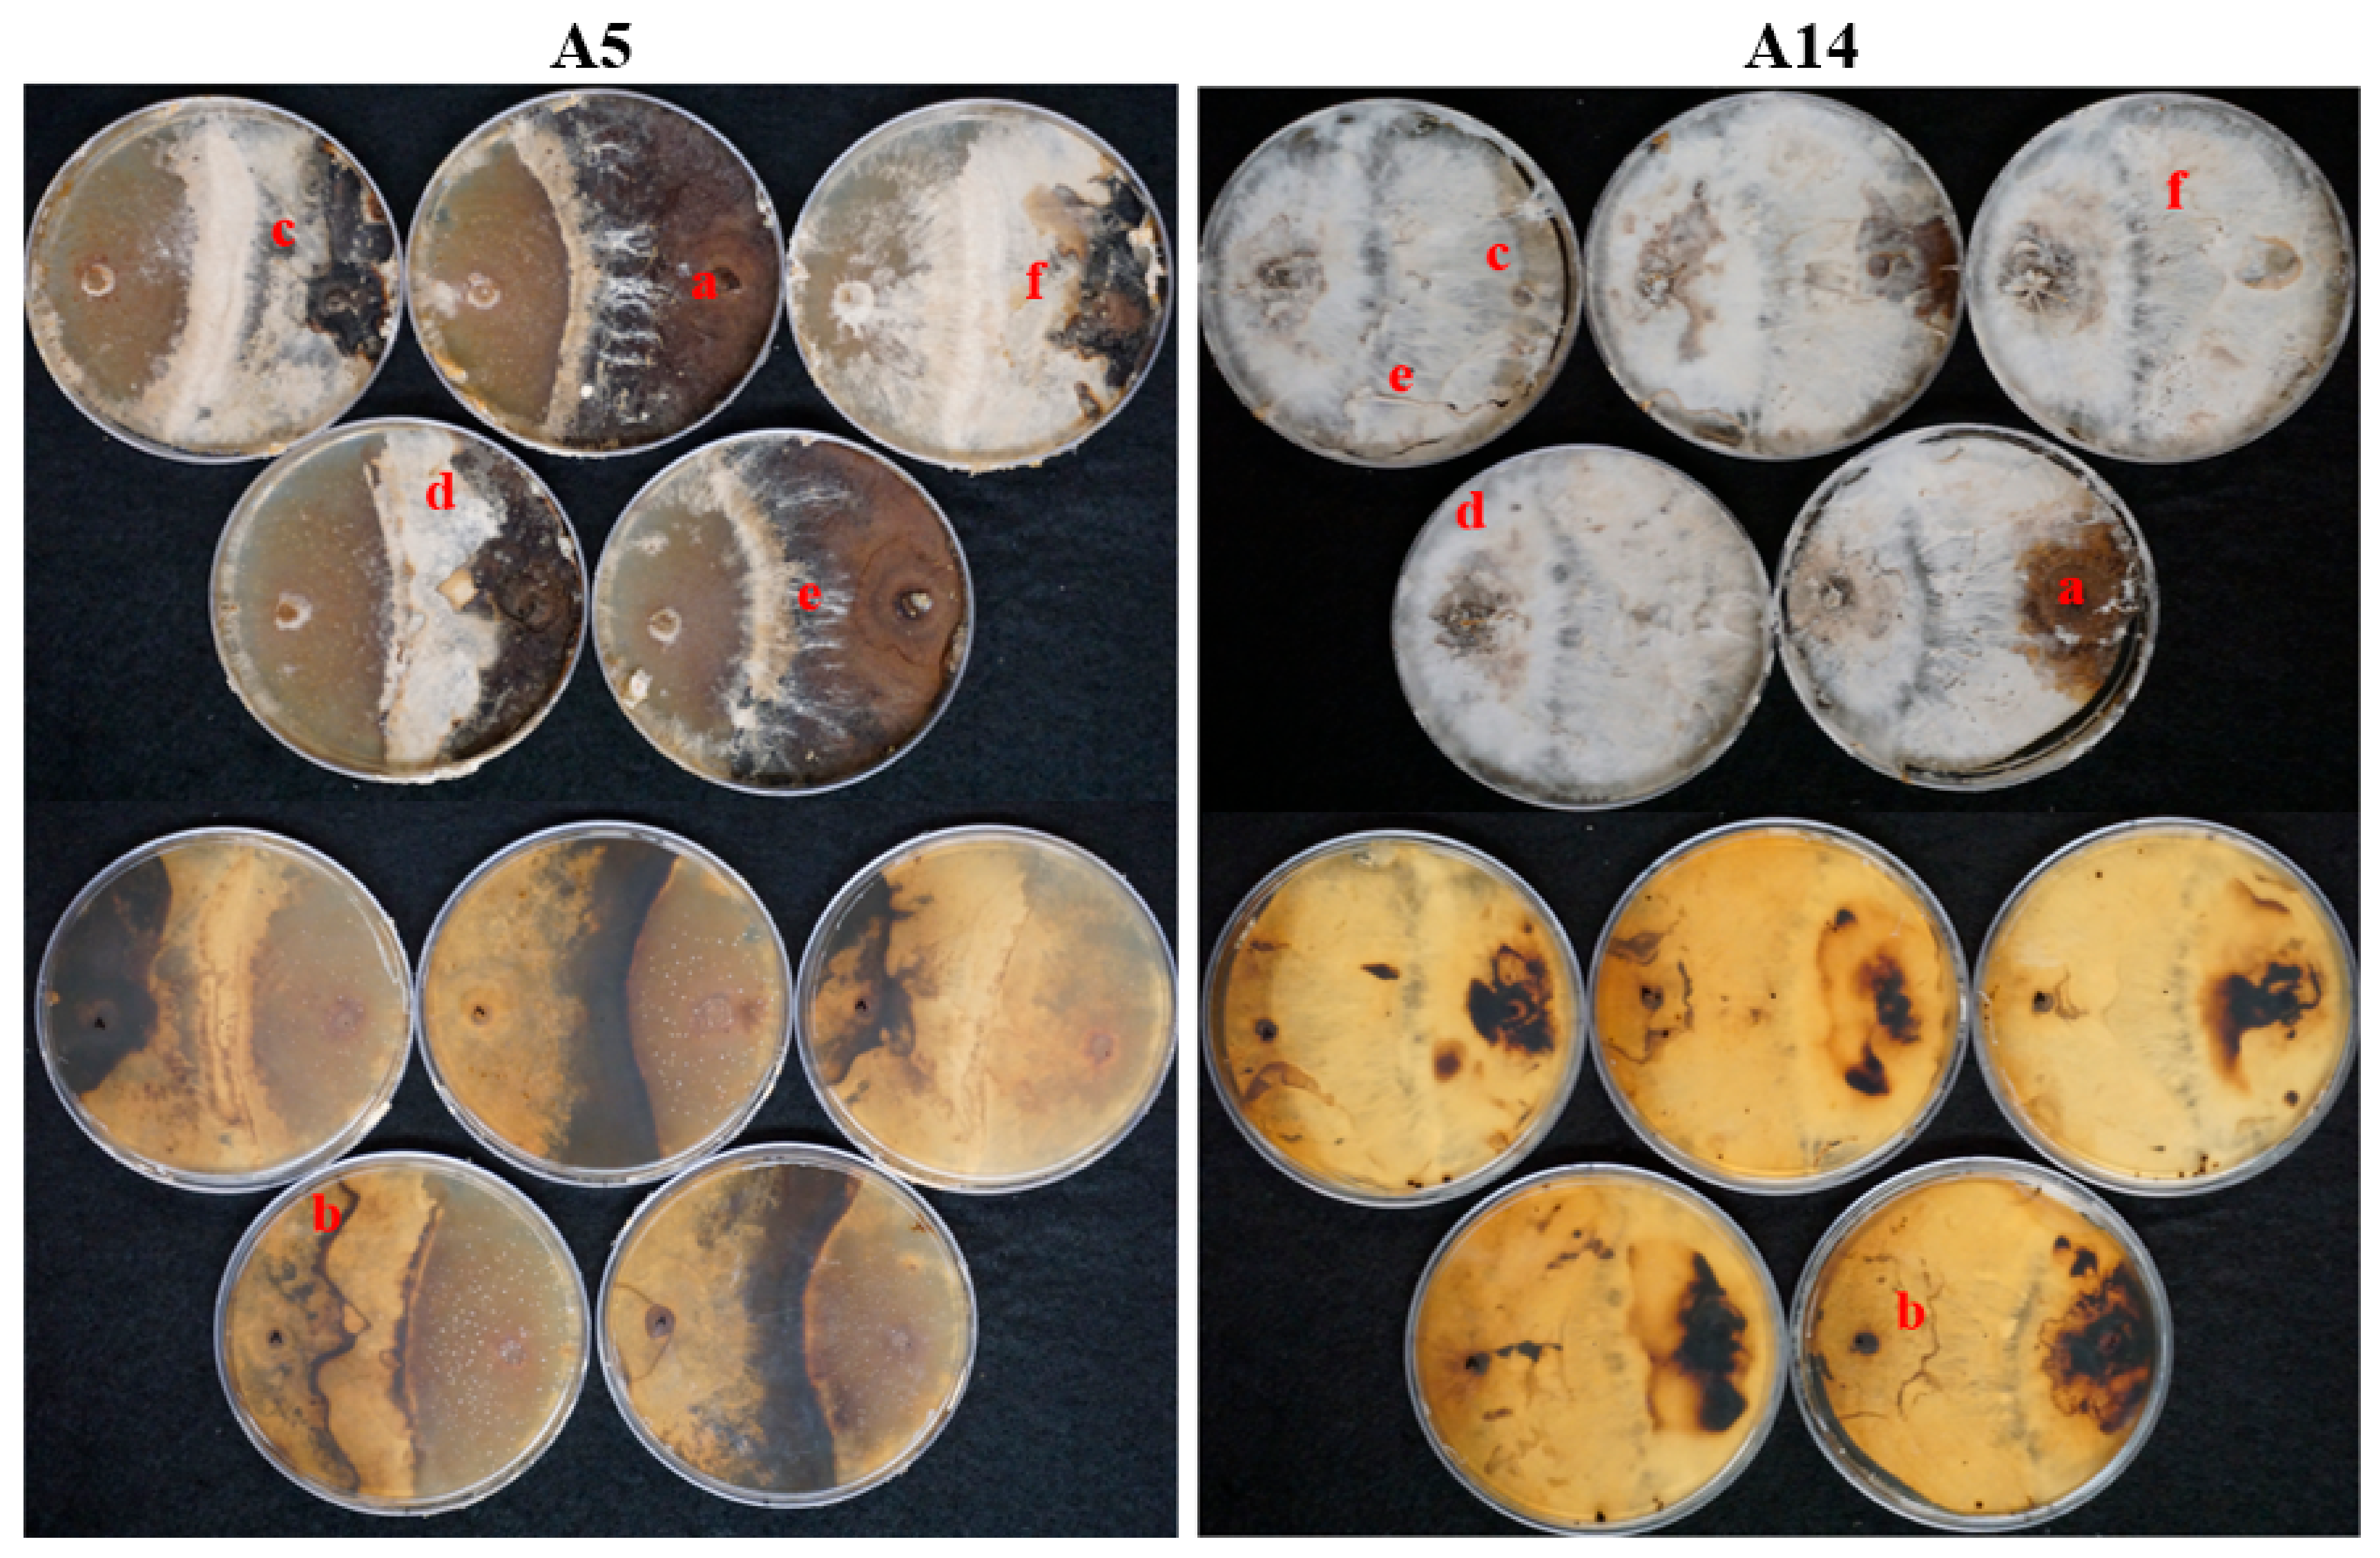
Jof 08 00203 g007 Jof 08 00203 g007

New Findings on the Biology and Ecology of the Ecuadorian Amazon Fungus Polyporus leprieurii var. yasuniensis
Abstract
1. Introduction
2. Materials and Methods
2.1. Competition Studies
2.2. Decay Study
2.3. Longevity and Survival
2.3.1. In Situ
2.3.2. Ex Situ
2.4. Elemental Analysis
3. Results
3.1. Competition Studies
3.2. Decay Study
3.3. Longevity and Survival
3.3.1. In Situ Longevity
3.3.2. Ex Situ Survival
3.4. Elemental Analysis
4. Discussion
4.1. Competition Studies
4.2. Wood-Decay Study
4.3. Longevity and Survival
4.4. Elemental Analysis
5. Conclusions
Supplementary Materials
Author Contributions
Funding
Institutional Review Board Statement
Informed Consent Statement
Data Availability Statement
Acknowledgments
Conflicts of Interest
References
- Gaston, K.J. Rarity, 1st ed.; Chapman & Hall: London, UK, 1994. [Google Scholar] [CrossRef]
- Kunin, W.E.; Gaston, K.J. The Biology of Rarity: Causes and Consequences of Rare-Common Differences, 1st ed.; Springer-Science Business Media: Dordrecht, The Netherlands, 1997. [Google Scholar] [CrossRef]
- Magurran, A.E.; Henderson, P. Explaining the excess of rare species in natural species abundance distributions. Nature 2003, 422, 714–716. [Google Scholar] [CrossRef] [PubMed]
- Arita, H.T.; Robinson, J.G.; Redford, K.H. Rarity in Neotropical Forest Mammals and its Ecological Correlates. Conserv. Biol. 1990, 4, 181–192. [Google Scholar] [CrossRef]
- Xu, H.; Detto, M.; Fang, S.; Li, Y.; Zang, R.; Liu, S. Habitat hotspots of common and rare tropical species along climatic and edaphic gradients. J. Ecol. 2015, 103, 1325–1333. [Google Scholar] [CrossRef]
- Hubbell, S.P. Tropical rain forest conservation and the twin challenges of diversity and rarity. Ecol. Evol. 2013, 3, 3263–3274. [Google Scholar] [CrossRef] [PubMed]
- Tovo, A.; Suweis, S.; Formentin, M.; Favretti, M.; Volkov, I.; Banavar, J.R.; Azaele, S.; Maritan, A. Upscaling species richness and abundances in tropical forests. Sci. Adv. 2017, 3, e1701438. [Google Scholar] [CrossRef] [PubMed]
- Bass, M.S.; Finer, M.; Jenkins, C.N.; Kreft, H.; Cisneros-Heredia, D.F.; McCracken, S.F.; Pitman, N.C.A.; English, P.H.; Swing, K.; Villa, G.; et al. Global Conservation Significance of Ecuador’s Yasuní National Park. PLoS ONE 2010, 5, e8767. [Google Scholar] [CrossRef] [PubMed]
- Toapanta-Alban, C.E. Diversidad del Orden Polyporales en un Área de Bosque Intervenido y un Área de Bosque Primario en la Estación Científica Yasuní. Bachelor Thesis, Facultad de Ciencias Exactas y Naturales, Quito, Ecuador, 2014. [Google Scholar]
- Toapanta-Alban, C.E.; Ordoñez, M.E.; Barnes, C.W.; Blanchette, R.A. Taxonomy of the major rhizomorphic species of the “Melanopus group” within Polyporaceae in Yasuní National Park, Ecuador. PLoS ONE 2021, 16, e0254567. [Google Scholar] [CrossRef] [PubMed]
- Montagne, J.P.F.C. Séconde centurie de plantes cellulaires exotiques nouvelles, Décades I et II. Ann. Des Sci. Nat. Bot. 1840, 13, 193–207. (In French) [Google Scholar]
- Núñez, M.; Ryvarden, L. Polyporus (Basidiomycotina) and Related Genera; Fungiflora: Oslo, Norway, 1995. [Google Scholar]
- MycoBank. Polyporus Leprieurii Mont. Available online: https://www.mycobank.org/page/Simple%20names%20search (accessed on 20 September 2021).
- Dai, Y.-C.; Xue, H.-J.; Vlasák, J.; Rajchenberg, M.; Wang, B.; Zhou, L.-W. Phylogeny and global diversity of Polyporus group Melanopus (Polyporales, Basidiomycota). Fungal Divers. 2013, 64, 133–144. [Google Scholar] [CrossRef]
- Zhou, J.-L.; Zhu, L.; Chen, H.; Cui, B. Taxonomy and Phylogeny of Polyporus Group Melanopus (Polyporales, Basidiomycota) from China. PLoS ONE 2016, 11, e0159495. [Google Scholar] [CrossRef]
- Palacio, M.; Robledo, G.L.; Reck, M.A.; Grassi, E.; Góes-Neto, A.; Drechsler-Santos, E.R. Decrypting the Polyporus dictyopus complex: Recovery of Atroporus Ryvarden and segregation of Neodictyopus gen. nov. (Polyporales, Basidiomyocta). PLoS ONE 2017, 12, e0186183. [Google Scholar] [CrossRef]
- Valencia, R. Yasuní. Available online: https://forestgeo.si.edu/sites/neotropics/yasuni (accessed on 12 January 2022).
- Shaw, C.G.; Kile, G.A. Armillaria Root Disease; Forest Service; United States Department of Agriculture: Washington, DC, USA, 1991. [Google Scholar]
- Shaw, C.G.; Kile, G.A.; Garraway, M.O. Ontogeny and Physiology. In Armillaria Root Disease; Forest Service; United States Department of Agriculture: Washington, DC, USA, 1991; pp. 21–47. [Google Scholar]
- Marçais, B.; Wargo, P.M. Impact of liming on the abundance and vigor of Armillaria rhizomorphs in Allegheny hardwoods stands. Can. J. For. Res. 2000, 30, 1847–1857. [Google Scholar] [CrossRef][Green Version]
- Agerer, R.; Iosifidou, P. Rhizomorph Structures of Hymenomycetes: A Possibility to Test DNA-Based Phylogenetic Hypotheses? In Frontiers in Basidiomycote Mycology; IHW-Verl.: Eching, Germany, 2004; pp. 249–302. [Google Scholar]
- Lamour, A.; Termorshuizen, A.J.; Volker, D.; Jeger, M.J. Network formation by rhizomorphs of Armillaria lutea in natural soil: Their description and ecological significance. FEMS Microbiol. Ecol. 2007, 62, 222–232. [Google Scholar] [CrossRef]
- Kubiak, K.; Żółciak, A.; Damszel, M.; Lech, P.; Sierota, Z. Armillaria Pathogenesis under Climate Changes. Forests 2017, 8, 100. [Google Scholar] [CrossRef]
- Sipos, G.; Prasanna, A.N.; Walter, M.C.; O’Connor, E.; Balint, B.; Krizsán, K.; Kiss, B.; Hess, J.; Varga, T.; Slot, J.; et al. Genome expansion and lineage-specific genetic innovations in the forest pathogenic fungi Armillaria. Nat. Ecol. Evol. 2017, 1, 1931–1941. [Google Scholar] [CrossRef]
- Yafetto, L. The structure of mycelial cords and rhizomorphs of fungi: A minireview. Mycosphere 2018, 9, 984–998. [Google Scholar] [CrossRef]
- Granlund, H.; Jennings, D.; Thompson, W. Translocation of solutes along rhizomorphs of Armillaria mellea. Trans. Br. Mycol. Soc. 1985, 84, 111–119. [Google Scholar] [CrossRef]
- Morrison, D. Vertical distribution of Armillaria mellea rhizomorphs in soil. Trans. Br. Mycol. Soc. 1976, 66, 393–399. [Google Scholar] [CrossRef]
- Held, B.W.; Salomon, C.E.; Blanchette, R.A. Diverse subterranean fungi of an underground iron ore mine. PLoS ONE 2020, 15, e0234208. [Google Scholar] [CrossRef]
- Smith, M.; Bruhn, J.N.; Anderson, J.B. The fungus Armillaria bulbosa is among the largest and oldest living organisms. Nature 1992, 356, 428–431. [Google Scholar] [CrossRef]
- Koch, R.A.; Lodge, D.J.; Sourell, S.; Nakasone, K.; McCoy, A.G.; Aime, M.C. Tying up loose threads: Revised taxonomy and phylogeny of an avian-dispersed Neotropical rhizomorph-forming fungus. Mycol. Prog. 2018, 17, 989–998. [Google Scholar] [CrossRef]
- Elliott, T.F.; Jusino, M.A.; Trappe, J.M.; Lepp, H.; Ballard, G.-A.; Bruhl, J.J.; Vernes, K. A global review of the ecological significance of symbiotic associations between birds and fungi. Fungal Divers. 2019, 98, 161–194. [Google Scholar] [CrossRef]
- Koch, R.A.; Liu, J.; Brann, M.; Jumbam, B.; Siegel, N.; Aime, M.C. Marasmioid rhizomorphs in bird nests: Species diversity, functional specificity, and new species from the tropics. Mycologia 2020, 112, 1086–1103. [Google Scholar] [CrossRef]
- César, E.; Montoya, L.; Bandala, V.M.; Ramos, A. Three new marasmioid-gymnopoid rhizomorph-forming species from Mexican mountain cloud forest relicts. Mycol. Prog. 2020, 19, 1017–1029. [Google Scholar] [CrossRef]
- Hedger, J.; Lewis, P.; Gitay, H. Litter-Trapping by Fungi in Moist Tropical Forest. In Aspects of Tropical Mycology; Published for the British Mycological Society by Cambridge University Press: Cambridge, UK, 1993; pp. 15–36. [Google Scholar]
- Lonsdale, D.; Pautasso, M.; Holdenrieder, O. Wood-decaying fungi in the forest: Conservation needs and management options. Eur. J. For. Res. 2007, 127, 1–22. [Google Scholar] [CrossRef]
- Marcot, B.G. A review of the role of fungi in wood decay of forest ecosystems. U. S. Dep. Agric. For. Serv. 2017, 575, 1–31. [Google Scholar] [CrossRef]
- Lustenhouwer, N.; Maynard, D.S.; Bradford, M.A.; Lindner, D.L.; Oberle, B.; Zanne, A.E.; Crowther, T.W. A trait-based understanding of wood decomposition by fungi. Proc. Natl. Acad. Sci. USA 2020, 117, 11551–11558. [Google Scholar] [CrossRef]
- Valencia, R.; Foster, R.B.; Villa, G.; Condit, R.; Svenning, J.-C.; Hernandez, C.; Romoleroux, K.; Losos, E.; Magard, E.; Balslev, H. Tree species distributions and local habitat variation in the Amazon: Large forest plot in eastern Ecuador. J. Ecol. 2004, 92, 214–229. [Google Scholar] [CrossRef]
- Blanchette, R.A.; Held, B.W.; Hellmann, L.; Millman, L.; Büntgen, U. Arctic driftwood reveals unexpectedly rich fungal diversity. Fungal Ecol. 2016, 23, 58–65. [Google Scholar] [CrossRef]
- Nicolotti, G.; Varese, G. Screening of antagonistic fungi against air-borne infection by Heterobasidion annosum on Norway spruce. For. Ecol. Manag. 1996, 88, 249–257. [Google Scholar] [CrossRef]
- Nikolajeva, V.; Petrina, Z.; Vulfa, L.; Alksne, L.; Eze, D.; Grantina, L.; Gaitnieks, T.; Lielpetere, A. Growth and Antagonism of Trichoderma spp. and Conifer Pathogen Heterobasidion annosum s.l. in Vitro at Different Temperatures. Adv. Microbiol. 2012, 2, 295–302. [Google Scholar] [CrossRef][Green Version]
- Woodward, S.; Boddy, L. Chapter 7: Interactions between Saprotrophic Fungi. In Ecology of Saprotrophic Basidiomycetes; Academic Press: London, UK, 2008; Volume 28, pp. 125–141. [Google Scholar]
- Doty, L. Gross Mycelial Contact—Fruit Bodies. Available online: https://www.ecologycenter.us/fruit-bodies/gross-mycelial-contact.html (accessed on 30 September 2021).
- Fichas Técnicas Para la Repoblación Forestal. Available online: https://ecuadorforestal.org/informacion-s-f-e/fichas-tecnicas-para-la-repoblacion-forestal/ (accessed on 1 October 2021).
- Schilling, J.S.; Jacobson, K.B. Agar-Block Microcosms for Controlled Plant Tissue Decomposition by Aerobic Fungi. J. Vis. Exp. 2011, 48, e2283. [Google Scholar] [CrossRef]
- Preston, F.W. The Commonness, And Rarity, of Species. Ecology 1948, 29, 254–283. [Google Scholar] [CrossRef]
- Verberk, W. Explaining General Patterns in Species Abundance and Distributions. Nat. Educ. Knowl. 2011, 3, 38. Available online: https://www.nature.com/scitable/knowledge/library/explaining-general-patterns-in-species-abundance-and-23162842/ (accessed on 19 October 2021).
- Mitchell, W.A.; Hughes, H.G. Fixed Area Plot Sampling for Forest Inventory. Technical Report EL-95-27; U.S. Army Corps of Engineers-Environmental Impact Research Program: Washington, DC, USA, 1995. [Google Scholar]
- Dahlberg, A.; Mueller, G.M. Applying IUCN red-listing criteria for assessing and reporting on the conservation status of fungal species. Fungal Ecol. 2011, 4, 147–162. [Google Scholar] [CrossRef]
- Boddy, L. Interspecific combative interactions between wood-decaying basidiomycetes. FEMS Microbiol. Ecol. 2000, 31, 185–194. [Google Scholar] [CrossRef]
- Hiscox, J.; O’Leary, J.; Boddy, L. Fungus wars: Basidiomycete battles in wood decay. Stud. Mycol. 2018, 89, 117–124. [Google Scholar] [CrossRef]
- Schoeman, M.W.; Webber, J.F.; Dickinson, D.J. The effect of diffusible metabolites of Trichoderma harzianum on in vitro interactions between basidiomycete isolates at two different temperature regimes. Mycol. Res. 1996, 100, 1454–1458. [Google Scholar] [CrossRef]
- Yeast Extract (NCM0218) Technical Specification Sheet NEOGEN Culture Media. PDF. Available online: https://www.neogen.com/categories/microbiology/yeast-extract/ (accessed on 27 October 2021).
- Malt Extract Agar (NCM0093) Technical Specification Sheet NEOGEN Culture Media. PDF. Available online: https://www.neogen.com/categories/microbiology/malt-extract-agar/ (accessed on 27 October 2021).
- Ronnie-Gakegne, E.; Martinez-Coca, B. Antibiosis and effect of pH-temperature on the antagonism of Trichoderma asperellum strains against Alternaria soloni. Rev. De Prot. Veg. 2018, 33, 1–9. [Google Scholar]
- Lodge, D.J. Nutrient Cycling by Fungi in Wet Tropical Forests. In Aspects of Tropical Mycology: Symposium of the British Mycological Society Held at the University of Liverpool, April 1992; Published for the British Mycological Society by Cambridge University Press: Cambridge, UK, 1993; pp. 37–57. [Google Scholar]
- Mattheck, C.; Schwarze, F.; Engels, J. Fungal Strategies of Wood Decay in Trees; Springer: Berlin, Germany, 2013. [Google Scholar]
- Presley, G.N.; Zhang, J.; Purvine, S.O.; Schilling, J.S. Functional Genomics, Transcriptomics, and Proteomics Reveal Distinct Combat Strategies Between Lineages of Wood-Degrading Fungi With Redundant Wood Decay Mechanisms. Front. Microbiol. 2020, 11, 1646. [Google Scholar] [CrossRef] [PubMed]
- Gaskell, J.; Blanchette, R.A.; Stewart, P.E.; BonDurant, S.S.; Adams, M.; Sabat, G.; Kersten, P.; Cullen, D. Transcriptome and Secretome Analyses of the Wood Decay Fungus Wolfiporia cocos Support Alternative Mechanisms of Lignocellulose Conversion. Appl. Environ. Microbiol. 2016, 82, 3979–3987. [Google Scholar] [CrossRef]
- Fukasawa, Y.; Matsukura, K. Decay stages of wood and associated fungal communities characterise diversity–decomposition relationships. Sci. Rep. 2021, 11, 1–12. [Google Scholar] [CrossRef] [PubMed]
- Bellassen, V.; Luyssaert, S. Carbon sequestration: Managing forests in uncertain times. Nature 2014, 506, 153–155. [Google Scholar] [CrossRef]
- Guevara, J.E.; Mogollón, H.; Pitman, N.C.A.; Cerón, C.; Palacios, W.A.; Neill, D.A. A Floristic Assessment of Ecuador’s Amazon Tree Flora. In Forest Structure, Function and Dynamics in Western Amazonia; Myster, R.W., Ed.; John Wiley & Sons Ltd.: Hoboken, NJ, USA, 2017. [Google Scholar] [CrossRef]
- Ter Steege, H.; Pitman, N.C.; Sabatier, D.; Baraloto, C.; Salomão, R.P.; Guevara, J.E.; Phillips, O.L.; Castilho, C.V.; Magnusson, W.E.; Molino, J.F.; et al. Hyper dominance in Amazonian tree flora. Science 2013, 342, 1243092. [Google Scholar] [CrossRef] [PubMed]
- Kirker, G.; Blodgett, A.; Arango, R.; Lebow, P.; Clausen, C. The role of extractives in naturally durable wood species. Int. Biodeterior. Biodegrad. 2013, 82, 53–58. [Google Scholar] [CrossRef]
- Weslien, J.; Djupström, L.B.; Schroeder, M.; Widenfalk, O. Long-term priority effects among insects and fungi colonizing decaying wood. J. Anim. Ecol. 2011, 80, 1155–1162. [Google Scholar] [CrossRef] [PubMed]
- Boddy, L.; Frankland, J.C.; van West, P.; Boddy, L.; Jones, T.H. Interactions between Basidiomycota and Invertebrates. In Ecology of Saprotrophic Basidiomycetes; Elsevier Academic Press: Amsterdam, The Netherlands, 2008; pp. 155–179. [Google Scholar]
- Fukasawa, Y.; Kaga, K. Effects of wood resource size and decomposition on hyphal outgrowth of a cord-forming basidiomycete, Phanerochaete velutina. Sci. Rep. 2020, 10, 1–8. [Google Scholar] [CrossRef] [PubMed]
- Casselman, A. Strange But True: The Largest Organism on Earth is a Fungus. Available online: https://www.scientificamerican.com/article/strange-but-true-largest-organism-is-fungus/ (accessed on 28 November 2021).
- Anderson, J.B.; Bruhn, J.N.; Kasimer, D.; Wang, H.; Rodrigue, N.; Smith, M.L. Clonal evolution and genome stability in a 2500-year-old fungal individual. Proc. R. Soc. B Boil. Sci. 2018, 285, 2233. [Google Scholar] [CrossRef]
- Watkinson, S.C.; Boddy, L.; Money, N.P.; Carlile, M.J.; Watkinson, S.C. Physiology and Adaptation. In The Fungi; Elsevier Academic Press: Amsterdam, The Netherlands, 2016; Chapter 5; pp. 141–187. [Google Scholar]
- Boddy, L. Saprotrophic cord-forming fungi: Warfare strategies and other ecological aspects. Mycol. Res. 1993, 97, 641–655. [Google Scholar] [CrossRef]
- Boddy, L. Saprotrophic Cord-Forming Fungi: Meeting the Challenge of Heterogeneous Environments. Mycologia 1999, 91, 13. [Google Scholar] [CrossRef]
- Certano, A.K.; Fernandez, C.W.; Heckman, K.A.; Kennedy, P.G. The afterlife effects of fungal morphology: Contrasting decomposition rates between diffuse and rhizomorphic necromass. Soil Biol. Biochem. 2018, 126, 76–81. [Google Scholar] [CrossRef]
- Dadachova, E.; Casadevall, A. Ionizing radiation: How fungi cope, adapt, and exploit with the help of melanin. Curr. Opin. Microbiol. 2008, 11, 525–531. [Google Scholar] [CrossRef]
- Eisenman, H.C.; Casadevall, A. Synthesis and assembly of fungal melanin. Appl. Microbiol. Biotechnol. 2011, 93, 931–940. [Google Scholar] [CrossRef]
- Gessler, N.N.; Egorova, A.S.; Belozerskaya, T.A. Melanin pigments of fungi under extreme environmental conditions (Review). Appl. Biochem. Microbiol. 2014, 50, 105–113. [Google Scholar] [CrossRef]
- Belozerskaya, T.A.; Gessler, N.N.; Aver‘Yanov, A.A. Melanin Pigments of Fungi. In Fungal Metabolites; Reference Series in Phytochemestry; Springer: Cham, Switerlands, 2017; pp. 263–291. [Google Scholar] [CrossRef]
- Pombeiro-Sponchiado, S.R.; Sousa, G.S.; Andrade, J.C.R.; Lisboa, H.F.; Gonçalves, R.C.R. Chapter 4: Production of Melanin Pigment by Fungi and Its Biotechnological Applications. In Melanin; In Tech: New York, NY, USA, 2017; pp. 47–75. [Google Scholar]
- Jacobson, E.S. Pathogenic Roles for Fungal Melanins. Clin. Microbiol. Rev. 2000, 13, 708–717. [Google Scholar] [CrossRef]
- Butler, M.J.; Day, A.W.; Henson, J.M.; Money, N.P. Pathogenic Properties of Fungal Melanins. Mycologia 2001, 93, 1599. [Google Scholar] [CrossRef]
- Liu, G.Y.; Nizet, V. Color me bad: Microbial pigments as virulence factors. Trends Microbiol. 2009, 17, 406–413. [Google Scholar] [CrossRef]
- Ribera, J.; Panzarasa, G.; Stobbe, A.; Osypova, A.; Rupper, P.; Klose, D.; Schwarze, F.W.M.R. Scalable Biosynthesis of Melanin by the Basidiomycete Armillaria cepistipes. J. Agric. Food Chem. 2018, 67, 132–139. [Google Scholar] [CrossRef]
- Wang, Y.; Aisen, P.; Casadevall, A. Cryptococcus neoformans melanin and virulence: Mechanism of action. Infect. Immun. 1995, 63, 3131–3136. [Google Scholar] [CrossRef]
- Kawamura, C.; Moriwaki, J.; Kimura, N.; Fujita, Y.; Fuji, S.-I.; Hirano, T.; Koizumi, S.; Tsuge, T. The Melanin Biosynthesis Genes of Alternaria alternata Can Restore Pathogenicity of the Melanin-Deficient Mutants of Magnaporthe grisea. Mol. Plant-Microbe Interact. 1997, 10, 446–453. [Google Scholar] [CrossRef]
- Grishkan, I. Ecological Stress: Melanization as a Response in Fungi to Radiation. In Extremophiles Handbook; Springer: Tokyo, Japan, 2011; pp. 1136–1143. [Google Scholar]
- Dadachova, E.; Casadevall, A. Melanin and Resistance to Ionizing Radiation in Fungi. In Extremophiles Handbook; Springer: Tokyo, Japan, 2011; pp. 1147–1157. [Google Scholar] [CrossRef]
- Dighton, J.; Tugay, T.; Zhdanova, N. Fungi and ionizing radiation from radionuclides. FEMS Microbiol. Lett. 2008, 281, 109–120. [Google Scholar] [CrossRef]
- Castelvecchi, D. Dark power: Pigment seems to put radiation to good use. Sci. News 2009, 171, 325. [Google Scholar] [CrossRef]
- Gorbushina, A.A.; Beck, A.; Schulte, A. Microcolonial rock inhabiting fungi and lichen photobionts: Evidence for mutualistic interactions. Mycol. Res. 2005, 109, 1288–1296. [Google Scholar] [CrossRef] [PubMed]
- Onofri, S.; Selbmann, L.; De Hoog, G.S.; Grube, M.; Barreca, D.; Ruisi, S.; Zucconi, L. Evolution and adaptation of fungi at boundaries of life. Adv. Space Res. 2007, 40, 1657–1664. [Google Scholar] [CrossRef]
- Cantrell, S.A.; Casillas-Martínez, L.; Molina, M. Characterization of fungi from hypersaline environments of solar salterns using morphological and molecular techniques. Mycol. Res. 2006, 110, 962–970. [Google Scholar] [CrossRef] [PubMed]
- Rizzo, D.M.; Blanchette, R.A.; Palmer, M.A. Biosorption of metal ions by Armillaria rhizomorphs. Can. J. Bot. 1992, 70, 1515–1520. [Google Scholar] [CrossRef]
- Fogarty, R.V.; Tobin, J.M. Fungal melanins and their interactions with metals. Enzym. Microb. Technol. 1996, 19, 311–317. [Google Scholar] [CrossRef]
- Tran-Ly, A.; Ribera, J.; Schwarze, F.W.; Brunelli, M.; Fortunato, G. Fungal melanin-based electrospun membranes for heavy metal detoxification of water. Sustain. Mater. Technol. 2019, 23, e00146. [Google Scholar] [CrossRef]
- Oh, J.-J.; Kim, J.Y.; Kim, Y.J.; Kim, S.; Kim, G.-H. Utilization of extracellular fungal melanin as an eco-friendly biosorbent for treatment of metal-contaminated effluents. Chemosphere 2021, 272, 129884. [Google Scholar] [CrossRef]
- Cordero, R.J.B.; Casadevall, A. Functions of fungal melanin beyond virulence. Fungal Biol. Rev. 2017, 31, 99–112. [Google Scholar] [CrossRef]
- Nosanchuk, J.D.; Stark, R.E.; Casadevall, A. Fungal Melanin: What do We Know about Structure. Front. Microbiol. 2015, 6, 1463. [Google Scholar] [CrossRef]
- McDougall, D.N.; Blanchette, R.A. Metal ion adsorption by pseudosclerotial plates of Phellinus weirii. Mycologia 1996, 88, 98. [Google Scholar] [CrossRef]
- Jenney, F.E., Jr.; Adams, M.W.W. Metalloproteins from Hyperthermophiles. In Extremophiles Handbook; Springer: Tokyo, Japan, 2011; pp. 521–545. [Google Scholar]
- Gadd, G.M. Interactions of fungi with toxic metals. New Phytol. 1993, 124, 25–60. [Google Scholar] [CrossRef]

| Collection Number | Taxa | Ecology and Origin | Melanin in Isolates | GenBank Number | |
|---|---|---|---|---|---|
| A | CT-16F | P. leprieurii var. yasuniensis | Wood-decay fungus, producing above ground rhizomorphs. Isolated from rhizomorphs. | Yes | MT950148 |
| 1 | M2 | Marasmius sp. 1 | Wood-decay fungus, producing aerial rhizomorphs. Isolated from rhizomorphs. | No | OM506563 |
| 2 | M4 | Marasmius sp. 2 | Wood-decay fungus, producing aerial rhizomorphs. Isolated from rhizomorphs. | No | OM506564 |
| 3 | CTR-3-1 | Russulales | Saprophyte fungus, isolated from senescent rhizomorphs. | No | OM506552 |
| 4 | CTR-3-9 | Hysterangiales | Mycorrhizae, hypogeous fungi (false-truffles). Isolated from cord-like mycelium colonizing living plants. | No | OM506553 |
| 5 | CTR-3-11 | Ascomycota 1 | Saprophyte fungus, isolated from canker on dying palm tree. | No | * |
| 6 | CTR-3-12B | Rhizoctonia papayae | Plant pathogen, isolated from basidiocarps of Rigidoporus sp. | No | OM506554 |
| 7 | CTR-3-11A | Ascomycota 2 | Parasitic or plant pathogen isolated from senescent rhizomorphs. | No | * |
| 8 | CTR-3-15A | Tinctoporellus sp. 1 | Wood-decay fungus, isolated from basidiocarps. | No | OM506555 |
| 9 | CTR-3-17A | Rhizoctonia sp. 2 | Plant pathogen, isolated from crust-like mycelium growing on leaf litter. | No | OM506556 |
| 10 | CTR-3-20 | Rigidoporus microporus | Wood-decay fungus, isolated from basidiocarps. | No | OM506557 |
| 11 | CTR-3-22B | Marasmius sp. 3 | Wood-decay fungus, isolated from sclerotia plates on decay wood. | No | OM506558 |
| 12 | CTR-3-24 | Ganoderma sp. 1 | Wood-decay fungus, isolated from basidiocarps. | Yes | OM506559 |
| 13 | CTR-3-26D | Caripia montagnei | Wood-decay, isolated from white mycelium on branches. | No | OM506560 |
| 14 | CTR-3-26B | Ascomycota 3 | Saprophyte, crust like fungus growing on decayed wood. It produces mycelial cords on media. Isolated from basidiocarps. | No | * |
| 17 | CTR-3-37 | Cristataspora coffeata | Wood-decay fungus, isolated from basidiocarps. | No | OM506561 |
| 18 | CTR-3-38 | Ganoderma weberianum | Wood-decay fungus, isolated from basidiocarps. | No | OM506562 |
| Common Name | Scientific Name | Density (g/cm3) | |
|---|---|---|---|
| 1 | Balsa | Ochroma pyramidale | 0.04 |
| 2 | Pachaco | Schizolobium parahyba | 0.41 |
| 3 | Melina | Gmelina arborea | 0.58 |
| 4 | Guayacan | Tabebuia chrysantha | 0.65 |
| 5 | Laurel | Cordia alliodora | 0.38–0.64 |
| 6 | Seike | Cedrelinga cateniformis | 0.45–0.55 |
| 7 | Teka | Tectona grandis | 0.61 |
| 8 | Saman | Samanea saman | 0.72–0.88 |
| 9 | Colorado | Guarea gomma | 0.52 |
| 10 | Cedro | Cedrela odorata | 0.48 |
| 11 | Moral | Chlorophora tinctoria | 0.89 |
| Code | Number of Jars | Treatment Conditions |
|---|---|---|
| 1 | 11 | 100 mL of deionized water added and no light exposure. |
| 2 | 11 | 100 mL of deionized water added and light exposure. |
| 3 | 10 | No water added and no light exposure. |
| 4 | 10 | No water added and light exposure. |
| 5 | 10 | No changes were made to these jars. No water was added, and jars were kept in a clear container with no direct light exposure. |
| Initial Observations | After 3 Years | ||||||
|---|---|---|---|---|---|---|---|
| Collection Site | Radius in Meters | Occupied Area m2 | Colonized Plants | Radius in Meters | Occupied Area m2 | Colonized Plants | Survival |
| * CT-16F | 40 | 5026.54 | 18 | 35 | 3848 | 14 | Yes |
| CTR-2-12 | 10 × 25 | 785 | 10 | 10 × 25 | 785 | 4 | Yes |
| CTR-2-27 | 10 | 314 | 6 | 15 | 706.86 | 9 | Yes |
| CTR-2-31 | 13 × 30 | 1225 | 16 | 13 × 30 | 1225 | 31 | Yes |
| CTR-2-67 | 12 | 425 | 3 | 14.5 | 660.51 | 27 | Yes |
| -Number of Rhizomorphs | Jars with Viable Rhizomorphs | % Survival of Jars | Observed Responses * | |||
|---|---|---|---|---|---|---|
| Treatment | Initial | Final | Initial | Final | ||
| 1 | 90 | 108 | 11 | 9 | 82 | A, C, E, F |
| 2 | 89 | 82 | 11 | 8 | 73 | A, B, C, D, E, F |
| 3 | 87 | 123 | 10 | 10 | 100 | C, D, E, F |
| 4 | 80 | 101 | 10 | 6 | 60 | B, C, D, E, F |
| 5 | 82 | 139 | 10 | 8 | 80 | B, C, D, F |
| Sample | Ca * | K * | P | Mg * | Al * | Si | Fe * | S | Mn * |
|---|---|---|---|---|---|---|---|---|---|
| Rhizomorph 1 | 3450.4 | 1708.2 | 978.95 | 809.44 | 668.40 | 439.24 | 398.46 | 361.91 | 100 |
| Wood 1 | 1235.3 | 288.27 | 205.61 | 664.59 | 10.186 | 26.794 | 16.695 | 323.96 | 25 |
| Rhizomorph 2 | 9707.0 | 1437.0 | 704.01 | 1333.4 | 297.11 | 323.93 | 89.572 | 567.59 | 56.35 |
| Wood 2 | 1868.5 | 249.16 | 131.88 | 1171.8 | 68.351 | 31.015 | 14.654 | 626.95 | 9.724 |
| Sample | Ba * | Sr * | Na * | Zn * | Cu * | B | Rb * | Ni * | Ti * |
| Rhizomorph 1 | 98.248 | 48.737 | 41.752 | 34.269 | 18.651 | 18.084 | 7.981 | 3.883 | 2.989 |
| Wood 1 | 69.756 | 100.92 | 7.029 | 4.729 | 5.395 | 3.922 | <0.074 | 3.681 | <0.003 |
| Rhizomorph 2 | 41.234 | 64.208 | 218.85 | 42.441 | 10.985 | 6.735 | 5.927 | 0.950 | 0.747 |
| Wood 2 | 66.939 | 160.74 | 34.983 | 25.682 | 2.620 | 6.676 | <0.074 | 2.164 | 0.084 |
| Sample | Cr * | V * | Cd * | Pb * | Co * | Li * | Mo * | Be * | |
| Rhizomorph 1 | 1.483 | 1.406 | 0.798 | 0.739 | 0.473 | 0.238 | 0.099 | 0.094 | |
| Wood 1 | 0.189 | 0.020 | 0.175 | 0.414 | 0.049 | 0.058 | <0.001 | <0.001 | |
| Rhizomorph 2 | 0.520 | 0.356 | 0.297 | 0.235 | 0.087 | 0.100 | <0.001 | <0.001 | |
| Wood 2 | 0.263 | 0.090 | 0.143 | 0.194 | <0.002 | 0.089 | <0.001 | <0.001 |
Publisher’s Note: MDPI stays neutral with regard to jurisdictional claims in published maps and institutional affiliations. |
© 2022 by the authors. Licensee MDPI, Basel, Switzerland. This article is an open access article distributed under the terms and conditions of the Creative Commons Attribution (CC BY) license (https://creativecommons.org/licenses/by/4.0/).
Share and Cite
Toapanta-Alban, C.E.; Ordoñez, M.E.; Blanchette, R.A. New Findings on the Biology and Ecology of the Ecuadorian Amazon Fungus Polyporus leprieurii var. yasuniensis. J. Fungi 2022, 8, 203. https://doi.org/10.3390/jof8020203
Toapanta-Alban CE, Ordoñez ME, Blanchette RA. New Findings on the Biology and Ecology of the Ecuadorian Amazon Fungus Polyporus leprieurii var. yasuniensis. Journal of Fungi. 2022; 8(2):203. https://doi.org/10.3390/jof8020203
Chicago/Turabian StyleToapanta-Alban, Cristina E., María E. Ordoñez, and Robert A. Blanchette. 2022. "New Findings on the Biology and Ecology of the Ecuadorian Amazon Fungus Polyporus leprieurii var. yasuniensis" Journal of Fungi 8, no. 2: 203. https://doi.org/10.3390/jof8020203
APA StyleToapanta-Alban, C. E., Ordoñez, M. E., & Blanchette, R. A. (2022). New Findings on the Biology and Ecology of the Ecuadorian Amazon Fungus Polyporus leprieurii var. yasuniensis. Journal of Fungi, 8(2), 203. https://doi.org/10.3390/jof8020203








